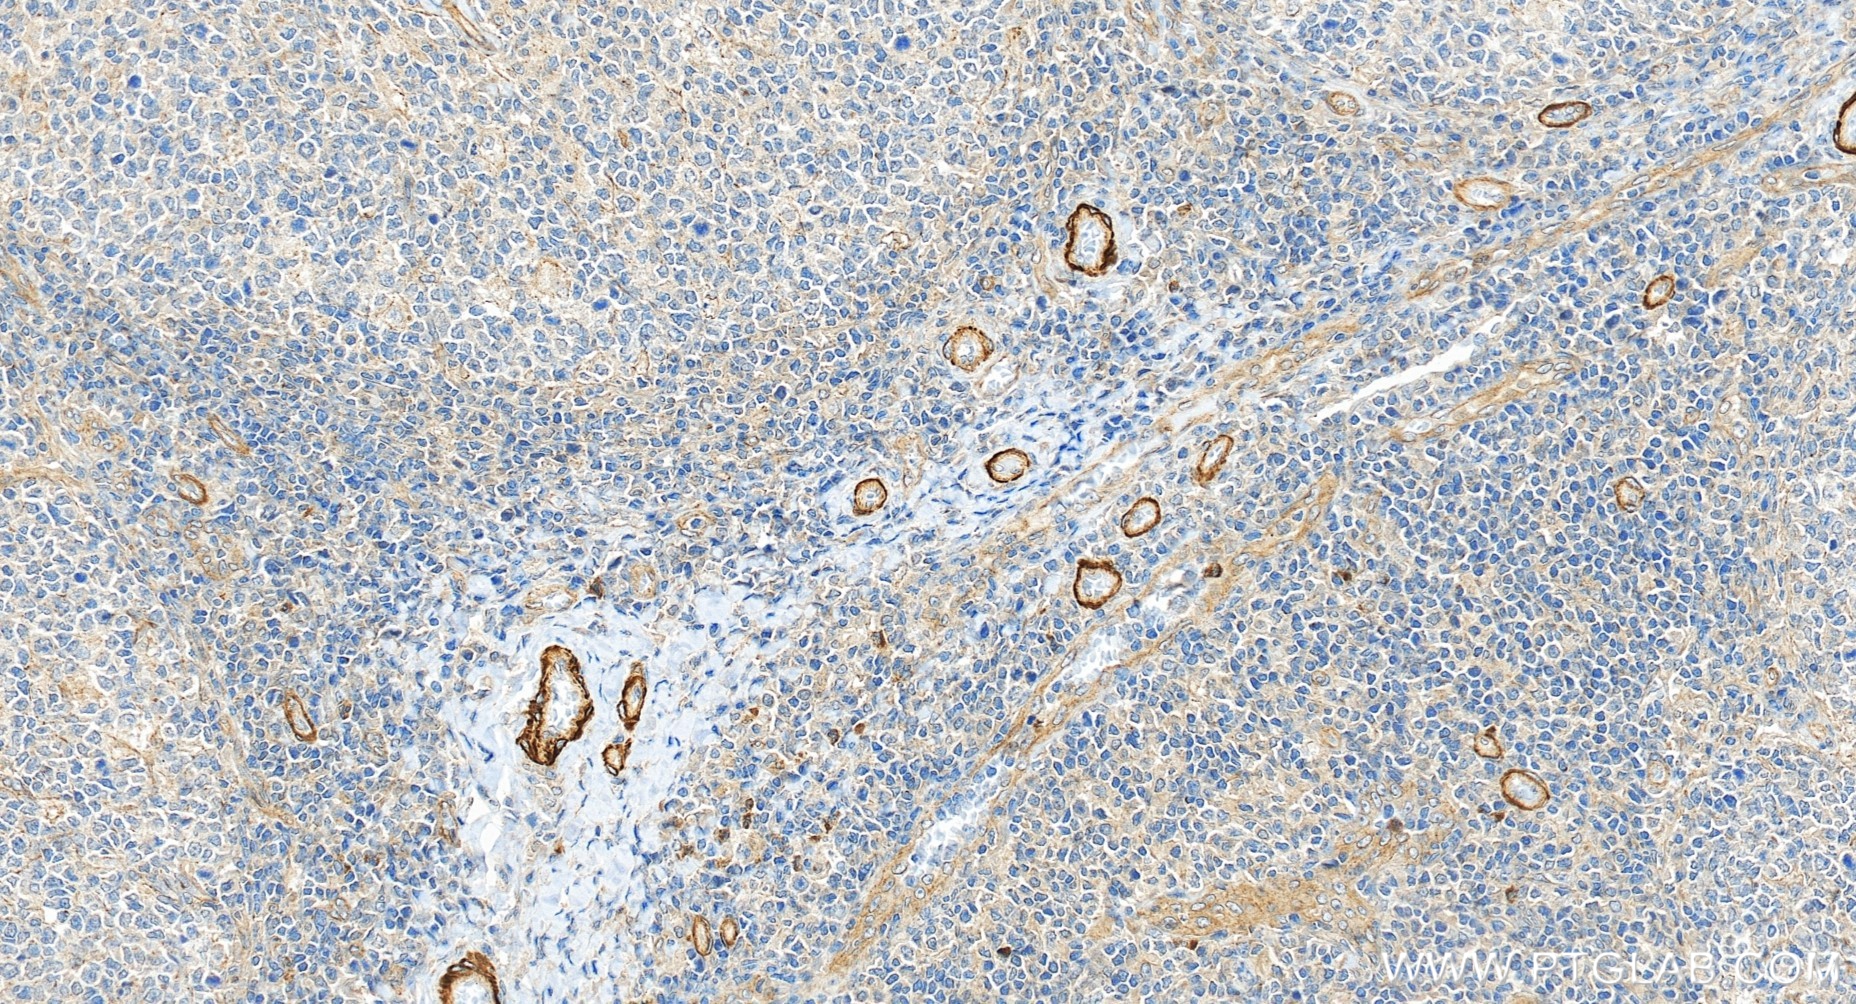
IHC staining of human tonsillitis using 84096-3-RR

验证数据展示
经过测试的应用
| Positive WB detected in | HUVEC cells, MDA-MB-231 cells |
| Positive IHC detected in | human tonsillitis tissue Note: suggested antigen retrieval with TE buffer pH 9.0; (*) Alternatively, antigen retrieval may be performed with citrate buffer pH 6.0 |
推荐稀释比
| 应用 | 推荐稀释比 |
|---|---|
| Western Blot (WB) | WB : 1:1000-1:6000 |
| Immunohistochemistry (IHC) | IHC : 1:250-1:1000 |
| It is recommended that this reagent should be titrated in each testing system to obtain optimal results. | |
| Sample-dependent, Check data in validation data gallery. | |
发表文章中的应用
| WB | See 1 publications below |
产品信息
84096-3-RR targets Pentraxin 3 in WB, IHC, ELISA applications and shows reactivity with human samples.
| 经测试应用 | WB, IHC, ELISA Application Description |
| 文献引用应用 | WB |
| 经测试反应性 | human |
| 文献引用反应性 | rat |
| 免疫原 |
CatNo: Eg1303 Product name: Recombinant Human Pentraxin 3 protein (His Tag) Source: mammalian cells-derived, pHZ-KIsec-C-6*HIS Tag: C-6*HIS Domain: 18-381 aa of NM_002852.4 Sequence: ENSDDYDLMYVNLDNEIDNGLHPTEDPTPCACGQEHSEWDKLFIMLENSQMRERMLLQATDDVLRGELQRLREELGRLAESLARPCAPGAPAEARLTSALDELLQATRDAGRRLARMEGAEAQRPEEAGRALAAVLEELRQTRADLHAVQGWAARSWLPAGCETAILFPMRSKKIFGSVHPVRPMRLESFSACIWVKATDVLNKTILFSYGTKRNPYEIQLYLSYQSIVFVVGGEENKLVAEAMVSLGRWTHLCGTWNSEEGLTSLWVNGELAATTVEMATGHIVPEGGILQIGQEKNGCCVGGGFDETLAFSGRLTGFNIWDSVLSNEEIRETGGAESCHIRGNIVGWGVTEIQPHGGAQYVS 种属同源性预测 |
| 宿主/亚型 | Rabbit / IgG |
| 抗体类别 | Recombinant |
| 产品类型 | Antibody |
| 全称 | pentraxin-related gene, rapidly induced by IL-1 beta |
| 别名 | PTX3, 241393D3, Pentaxin related protein PTX3, Pentaxin-related protein PTX3, Pentraxin related protein PTX3 |
| 计算分子量 | 42 kDa |
| 观测分子量 | 42 kDa |
| GenBank蛋白编号 | NM_002852.4 |
| 基因名称 | Pentraxin 3/PTX3 |
| Gene ID (NCBI) | 5806 |
| RRID | AB_3671662 |
| 偶联类型 | Unconjugated |
| 形式 | Liquid |
| 纯化方式 | Protein A purification |
| UNIPROT ID | P26022 |
| 储存缓冲液 | PBS with 0.02% sodium azide and 50% glycerol, pH 7.3. |
| 储存条件 | Store at -20°C. Stable for one year after shipment. Aliquoting is unnecessary for -20oC storage. |
背景介绍
Pentraxin 3 (PTX3), also known as TNF-inducible gene 14 protein (TSG-14), is a member of the pentraxin superfamily which consists of evolutionarily conserved proteins characterized by a structural motif99, the pentraxin domain (PMID: 15771574). Pentraxin 3 can be produced by a variety of cell types including endothelial cells, smooth muscle cells, adipocytes, fibroblasts, mononuclear phagocytes, and dendritic cells, and its expression is induced by primary inflammatory signals, such as IL-1, TNF, and microbial moieties (PMID: 15771574). Pentraxin 3 is an acute phase glycoprotein that plays a role in regulating innate resistance to pathogens, inflammation, tissue remodeling and repair, female fertility, and cancer (PMID: 29412047). Pentraxin 3 is a biomarker for cardiovascular disease (PMID: 22347626). Increased plasma Pentraxin 3 levels have been found in patients with cardiovascular disorders (PMID: 22347626; 31057548). In WB, there're two major bands, an upper signal at 80-86 kDa and a lower signal at 42 kDa, representing Pentraxin 3 dimers and monomers, respectively (PMID: 18223257).
实验方案
| Product Specific Protocols | |
|---|---|
| IHC protocol for Pentraxin 3 antibody 84096-3-RR | Download protocol |
| WB protocol for Pentraxin 3 antibody 84096-3-RR | Download protocol |
| Standard Protocols | |
|---|---|
| Click here to view our Standard Protocols |